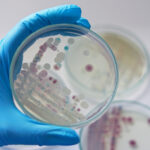

Привычка, которая стоит слуха: чем грозит ежедневное использование наушников

Постоянное прослушивание музыки в наушниках может наносить серьезный вред здоровью органов слуха и не только. Регулярное воздействие звуковых волн высокой интенсивности непосредственно в ушной канал приводит к необратимым изменениям. Многие люди недооценивают риски, связанные с этой привычкой, пока не сталкиваются с проблемами.
Потеря слуха развивается постепенно из-за повреждения волосковых клеток внутреннего уха. Ушные инфекции возникают при использовании чужих наушников или недостаточной гигиене. Головные боли появляются из-за постоянного давления на ушную раковину и звуковой нагрузки. Снижение концентрации наблюдается при длительном использовании шумоподавляющих наушников. Изоляция от окружающей среды повышает риск несчастных случаев на улице. Секрет безопасного прослушивания заключается в соблюдении правила 60/60 — не превышать 60% громкости и делать перерывы каждые 60 минут. Предпочтение стоит отдавать накладным наушникам вместо вакуумных моделей.
Ранее сообщалось об утренних привычках, которые делают старше. Избегайте этого, и ваш организм обязательно отблагодарит.